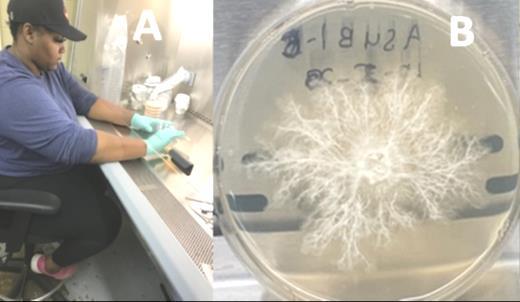

ALCORN STATE UNIVERSITY
COLLEGE OF AGRICULTURE & APPLIED SCIENCES
![]()

ALCORN STATE UNIVERSITY
COLLEGE OF AGRICULTURE & APPLIED SCIENCES





• To better serve our students, particularly in the area of poultry and agricultural sciences
• To provide resources to better assist with training the next level of the workforce with careers in poultry science and animal science
• To better serve the youth of the state through our Extension programs
• To better serve the community including our farmers and ranchers, helping them become more profitable
• To attract the best talent
• To evolve and meet the needs in research and education to continue meeting the needs of our society
Strengthen poultry research, training and production.
Increase the number of MS Youth reached with 4H programs.
Increase corporate partnerships.
Increase the number of youth entering agricultural careers.
Enhancing partnerships with our peer universities.
Increase pea production and marketing in the MS Delta. Enhance shitake mushrooms research and production.
Increase profitability and productivity of small and disadvantaged farmers and ranchers.
Facility improvement.
Academic Units Department of Agriculture
Department of Advance Technology
Department of Human Sciences
Extension
Product
Development Center
Small Farm Incubator
Vegetable Processing Center
Mound Bayou Pea
Project
MS Small Farm and Agribusiness Center
Experiment Station
Research
MS River Research Center Center for Conservation Research
Projects – Mushrooms, Poultry, Greenhouses, Farms
19 USDA Scholars and 12 Pathway
Hired 6 new faculty with joint appointments in research, extension and education – the tripartite system
Over 60 students participated in summer internships
13 Thurgood Marshall interns worked in USDA agencies across four states
Projects – Mushrooms, Poultry, Greenhouses, Farms
Projects – Mushrooms, Poultry, Greenhouses, Farms
Hired over 10 new support staff, post-docs, and research scientist
Provided professional development for faculty and staff
Domestic and international student recruitment
Enhanced collaboration with MSU in research, program development, etc.
Agriculture students are at the top of the student government association
12 recently graduates went straight to USDA jobs
Secured a larger variety of animals to the farms to enhance educational training for the students and the community
Financial efforts helped secured $2 million in funds to support STEM outreach activities virtually to rural MSschools
Purchase of much needed equipment, upgrades,






federal and state matching funds

Extension Appropriations, $3,100,000




DEPARTMENT OF AGRICULTURE

DEPARTMENT OF HUMAN SCIENCES

DEPARTMENT OF ADVANCE TECHNOLOGIES

Grant Number Agency Grant Title
2020-38821-31088 USDA-NIFA-CBG Enhancing Food Security in Rural Mississippi through Family farming Initiatives
2020-38821-31123
2020-38821-31092
2021-38821-34582
2021-38821-34727
2022-38821-37335
USDA-NIFA-CBG Predicting Vineyard Canopy Coverage Using Airborne Images and Neural Network
USDA-NIFA-CBG Evaluation of Under-Utilized Tree Crop, R heudelotii (Tropical oilseed ) as a Functional Feed for Production of Omega-3 Enriched Pork
USDA-NIFA-CBG Engineering Impact-Resistant Hydrophobic Microcrystalline Cellulose Biocomposites Using Switchgrass, Giant Miscanthus, And DDGS
USDA-NIFA-CBG Integrating Sustainable Agricultural Practices to Enhance Quality of Poultry Products and Environment in Southwest Mississippi
USDA-NIFA-CBG Acquisition of Scientific Instrumentation for Agricultural Microbiology Instruction
2022-38821-37359 USDA-NIFA-CBG Developing Sweetpotato Germplasms with Increased Protein Levels and Improved Viral Disease Resistance
2023-38821-39808
2023-38821-39880
2023-38821-39922
2024-38821-42043
2024-38821-42047
2024-38821-42093
2024-38821-42083
2024-38821-42125
USDA-NIFA-CBG Enhancing Agricultural Education For The 21st Century Global Economy
USDA-NIFA-CBG Introducing And Integrating Stevia Into Rural Mississippi Farm Operations To Improve Community Health And Income
USDA-NIFA-CBG Crop Genetic Enhancement Through Genome Editing Technology and Future Agriculture Leadership Cultivation
USDA-NIFA-CBG 1890-HSI Partnership To Enhance Graduate Competitiveness And Faculty Knowledge In Tropical Agriculture
USDA-NIFA-CBG Professional Development On Unmaned Aerial Vehicales (UAV)
USDA-NIFA-CBG Strengthening Food Systems in an Era of Extreme Weather
USDA-NIFA-CBG Enhancing Crop Stress Tolerance Through Beneficial Microbes And Future Agriculture Workforce Development
USDA-NIFA-CBG Education And Application Of Portable Crop Disease Detection Technologies To Improve Biosecurity For The Underserved Family Farms In Ms & Ak
NR203A750025C002 USDA-NRCS Training the Next Generation of USDA-NRCS UAV Pilots in Soil Conservation Applications
NR204423XXXXC114
NR204423XXXXC005
NR233A750023C006
USDA-NRCS Enhance Small-Farm Community and Training of the Next Generation of Agricultural Scientists
USDA-NRCS Using Novel Sensor Tech in MS
USDA-NRCS Promote multidiscipline collaborations with Alcorn State university (ASU) and inter-institutional collaborations between ASU and USDA NRCS scientists through the study of field soil and climate data
5 projects from USDA-CBG were awarded for a total of 1.8 million dollars.
3 USDA-NRCS awards with a total fund of $ 1.8 million awarded.
USDA climate smart opportunity awarded at 2.8 million dollars.
US Department of Commerce awarded Alcorn as subawardee for 1.5 million dollars on Computer Aided Virtual Environment (CAVE) projects.
$18 million collaboration grant received for NextGen, $1.5 million of the total goes to CAAS, PI’s Wakefield and Zhang
$3 million awarded to CAAS from the USDA-NRCS and Natural Resources and Environment, Terry Cosby, Homer Wilkes













Research focus:
• Poultry Nutrition
• Poultry Production and Management
• Food Safety Egg



DR. FRANK MREMA

Poultry/Animal Science
Academic Research Center
Phase II
Total Budget: $3,677,100

Small ruminant animal Research and Production



• 2024 Extension Program Impact
• Location and Program Areas
• Agriculture and Natural Resources 2024 Impact

• Community Resource Development (CRD) 2024 Impact
• Off-Campus Centers 2024 Impact
• 4-H and Youth Development 2024 Impact
• Family and Consumer Sciences (FCS) 2024 Impact
• Product Development Center (PDC)
• 2024 Extension Funding
• ASU Extension Collaborations




17 Counties and 3 off-campus centers
Agriculture & Natural Resources
4-H and Youth Development
Family & Consumer Sciences
Community and Resource Development
Off-Campus Centers

• Assisted over 40,000 small-scale and minority farmers in adopting sustainable farming practices.
• More than 800 events/outreach activities were conducted.
• Reduced production costs through education on low-cost farming practices.
• Economic Impact: Over $146.5 million.
Community and Container Gardening
• 245 workshops
• 16 counties
• 1,344 individuals reached
Farm Management Program
• 20 Workshops
• 5 counties
• 681 individuals reached
Model Farm Education Program
• 225 Field visits (group/individual)
• 902 individuals reached
Crop Production Program
• 199 workshops/events
• 17 counties
• 2,152 individuals reached
MS Small Farm Agribusiness Center
• 13 workshops
• 20 counties
• 674 participants reached
Integrated Pest Management (IPM)
• 306 workshops
• 16 counties
• 3,030 individuals reached



Animal Science Education Program
• 29 workshops
• 12 counties
• 95 participants reached
Soil Nutrient Management Program
• 101 meetings
• 12 counties
• 950 participants reached
Livestock Production Program
• 29 workshops
• 13 counties
• 95 participants reached








• Reached over 116,000 youths in Mississippi through STEM, leadership, and agricultural programs.
• More than 200 events/outreach activities were conducted.
• Increased college enrollment rates among program participants.
• Economic Impact: Over $2.2 million.

Career and Workforce Development
• 26 workshops
• 14 counties
• 25,700 individuals reached
Youth Leadership Development Program
• 25 workshops
• 14 counties
• 4,579 participants reached
4-H Healthy Living Program
• 108 workshops & 10 summer camps
• 25 counties
• 16 school
4-H STEM Challenge Program
• 20 challenges
• 24 counties
• 2,098 individuals reached
Risky Behavior Educational Program
• 16 Workshop
• 12 Counties
• 8,678 participants reached


Through a variety of hands-on workshops, program, events, activities, conferences, health fairs, valuable educational information was provided to limited resource children, youth and families across Mississippi. This information focused on strategies to enhance health and wellbeing. During the fiscal year 2023-2024, the program reached 24,242 participants, resulting in an economic impact exceeding $36,363.00.

Nutrition Education Program
• 336 workshops
• 15 counties
• 12,251 participants reached
Parenting Education Program
• 81 workshops
• 15 counties
• 5,029 individuals reached
Family Financial Management Program
• 20 workshops
• 15 counties
• 690 participants reached
Healthy Eating/Diet Program
• 273 activities
• 15 counties
• 11,697 individuals reached


• Promoted healthy eating and physical activity to over 24,000 residents across Mississippi.
• Delivered over 700 events/outreach activities to enhance the health and well-being of limited-resource families.
• Provided training on nutrition education, improving access to fresh produce.
• Economic Impact: Over $3.6 million.
Leadership Skills Development Program
• 12 workshops
• 16 counties
• 84 individuals reached Crop Insurance Agents/Adjusters
Workforce Development Program
• 24 Workshop
• 12 Workshop
• 360 participants reached
• 4 online trainings
• 13 counties
• 25 individuals reached
Estate Planning/Heir Property
• 11 workshops
• 10 counties
• 291 individuals reached
Small Farmers Conference
• 1 workshop
• 1 county
• 300 individuals reached
Farmers and Mobile Market Program
• 27 workshops
• 12 counties
• 485 participants reached






• Off-campus centers are utilized to educate limited-resource farmers on varietal, cultural, and fertilizer application methods on selected small fruits and vegetables that show promise as income-generating crops
• A total of 116 events/outreach activities were delivered that promote public awareness of Farm Bill provisions.
• The vegetable processing and packing facility assists small farmers in the North Delta area in producing and processing commercial vegetables in order to diversify their farm operations and improve their marketing potential.
• These centers reached direct and indirect contacts with 7,500 clients having a total economic impact of $36 Million
Mound Bayou Extension/Research Farm (Bolivar County)
• 15 workshops/events
• 3 field days/ demonstration
• Reached 5017 individuals
Preston Incubator Farm (Kemper County)
• 5 workshops/events
• 1 field day
• Reached 2116 individuals

Marks Vegetable Processing Plant (Quitman County)
• 14,315 lbs. of peas processed 5,000 lbs. of vegetables processed
• 13 workshops




The mission of the Center is to provide - Teaching, Research, and Outreach activities:
• An avenue for small farmers and entrepreneurs to receive technical assistance in developing and marketing value-added agricultural products.
• A learning environment where Alcorn’s students and small farmers/entrepreneurs will have an opportunity to gain hands-on experience with value-added processing and production.
• During the 2023-2024 period, the center is used as a retail store to sell 24 value-added products, such as hot sauce, spices, wing sauce, pickled products, etc., to the public and has generated over $20,000 in revenue.
• A total of 502 visitors received training on value-added products and their preservation techniques.
















